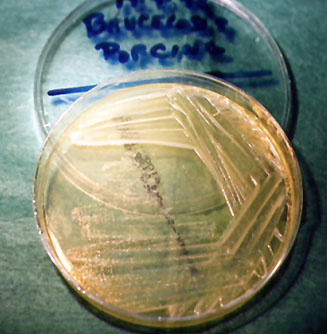

Diagnóstico
Directo:
La bacteriología rutinaria ante sospechas de brucelosis
debe incluir la tinción de
improntas además de mediante la técnica de Gram,
con la específica de Stamp, y el aislamiento en medios
de cultivo selectivos como el Farrel y el Thayer Martin modificado
que, al incluir en su composición antibióticos
y antifúngicos para evitar contaminaciones, son idóneos
para el aislamiento de brucelas de muestras que, frecuentemente,
están contaminadas con otros microorganismos. La tinción
de improntas mediante la técnica de Stamp, si es positiva,
es presuntiva, siendo imprescindible el aislamiento, para que
el diagnóstico sea definitivo. |
|

BRUCELOSIS: Brucelas, tinción
de Stamp positiva.
|
|
BRUCELOSIS: B. suis: crecimiento
en medio selectivo de Farrel.
|
|

BRUCELOSIS: B. suis: crecimiento
en Agar Sangre.
|
|
En ocasiones a partir de muestras fetales (hígado,
pulmón, bazo y contenido gástrico) es posible
realizar el aislamiento en medios nutritivos comunes como
el Agar Sangre.
|
|

BRUCELOSIS: Toma de muestra vaginal mediante
hisopo.
|
|
Se consideran muestras de elección las secreciones
vaginales tras parto y/o aborto, así como leche e incluso
semen. La excreción de brucelas por vagina se produce
de forma masiva incluso hasta 30 días post parto. La
eliminación por leche suele realizarse de forma poco
intensa y discontinua, por lo que en ocasiones el aislamiento
no resulta exitoso. Es frecuente, al igual que en otras especies,
que no exista aislamiento positivo a partir del feto y sí
lo haya a partir de escobillones de exudados fetales, como
consecuencia de la infección placentaria (placentitis)
pero no fetal.
|
| A partir de matadero, la toma
de muestras de ganglios retromamarios, iliacos y retrofaríngeos,
bazo, glándula mamaria y útero, y tras realizar
un macerado, también pueden ser muy útiles.
Por otro lado, y a pesar que algunos autores indican que
la congelación de muestras y órganos no influye
en la viabilidad de las bacterias en las muestras, al menos
durante un cierto tiempo, nuestro criterio es realizar el
análisis bacteriológico lo antes posible.
|
|
Diagnóstico indirecto
Serológico: detectamos
la respuesta inmune mediada por anticuerpos,
mediante técnicas serológicas.
Todos los biovares de Brucella suis
que afectan al cerdo poseen el mismo antígeno
A inmunodominante que la mayoría de los biovares
de Brucella abortus. Por esta razón los biovares
de B. abortus resultan apropiados para el análisis
de sueros porcinos (O.I.E. 3.5.2.);
por ello el uso del Rosa de Bengala y otras técnicas,
aunque no empleen antígeno brucelar porcino, puede
resultar apropiado.
BRUCELOSIS:
Rosa de Bengala modificado (Dilución 75 µl de
suero problema / 25 µl de Rosa de Bengala). ®
|
|

|
| En brucelosis porcina se han
empleado multitud de pruebas serológicas: Aglutinación
en Tubo, Microaglutinación en Placa, Aglutinación
Rápida (Rosa de Bengala), Fijación del Complemento,
Inmunodifusión Radial, ELISA-indirecto y ELISA-competición. |
|

|
|
El empleo de pruebas serológicas en el diagnóstico
de la brucelosis porcina, presenta la ventaja de que son sensibles
y aplicables a un gran número de muestras y el inconveniente
de su baja especificidad y de no estar debidamente estandarizadas
en porcino.
La existencia de reacciones serológicas
cruzadas con otras bacterias gram negativas, con gran
similitud en el lipopolisacárido externo como Yersinia
enterocolítica serotipo O9, algunos serotipos
de Salmonella y E. coli, Francisella tularensis,
etc. puede originar la aparición de falsos
positivos.
¬ BRUCELOSIS:
inmunodifusión radial (izquierda) y Difusión
Doble (derecha).
|
| Las pruebas de diagnóstico
indirecto que valoran la respuesta inmune mediada por células,
sí evitan la inespecificidad de la serología.
La prueba de estimulación linfocitaria, el y-interferón
y la prueba de hipersensibilidad retardada (para esta prueba
ver apartado anterior) son tres métodos que están
infravalorados, pero que poseen una especificidad elevadísima. |
|
En el análisis histológico
se observan células gigantes multinucleadas, células
tipo Langhans y los característicos
granulomas tuberculosos con focos de necrosis central, rodeados
de las típicas células inflamatorias.
La tinción de improntas mediante las técnicas
de Zielh-Neelsen o de la Auramina ayuda a orientar el diagnóstico.
La evidencia de bacterias Zielh-Neelsen
o Auramina positivas en lesiones, representa un diagnóstico
asertivo de la enfermedad, si bien cabe señalar que
la cantidad de micobacterias que existe en las muestras patológicas
es directamente proporcional al grado de lesión
exudativa. En las lesiones proliferativas
en no pocas ocasiones no se observan bacilos o, si los hay,
aparecen en muy bajas cantidades.
|
|

TUBERCULOSIS: Células de Langhans
(Hematoxilina-Eosina).
|
|

TUBERCULOSIS: Zielh-Neelsen (tinción
positiva).
|
|
El aislamiento
en diversos medios de cultivo específicos, previa descontaminación
de la muestra, es, como en casi todos las enfermedades de
etiología bacteriana, un paso esencial para poder obtener
un diagnóstico seguro, a pesar de ser un proceso lento
y engorroso en estas bacterias. Aunque en la actualidad, en
laboratorios preparados, se dispone de técnicas de
PCR, éstas, por el momento
no pueden sustituir al cultivo e identificación tradicionales,
en el proceso global del diagnóstico, aunque permiten
encuadrar el mismo, tras el aislamiento, de una forma más
rápida.
Si bien la serología
no tiene interés en colectivos porcinos, la valoración
de la respuesta de tipo celular de forma indirecta mediante
la técnica del Y-Interferón,
se ha mostrado en nuestras manos tremendamente eficaz para
la realización de campañas de saneamiento de
explotaciones en extensivo, si bien es una técnica
que debe ser realizada en laboratorios con experiencia y medios
suficientes para su correcto desarrollo.
|
|

TUBERCULOSIS: M. bovis: crecimiento
en medio sólido en tubo.
|
|
Histológicamente se observa
un aumento de permeabilidad vascular y la presencia de microtrombos
en capilares, que ocasionan necrosis isquémica perivascular
con coagulopatía generalizada y estado de "shock".
El diagnóstico serológico
carece de interés, mientras que el diagnóstico
microbiológico es definitivo. La tinción
de improntas de órganos vitales y sangre (con la observación
de bacilos cortos Gram positivos),
es meramente orientativa. En Agar Sangre se pueden observar
colonias circulares muy pequeñas y débilmente
hemolíticas tras 48 horas de incubación.
|
| 
MAL ROJO: Impronta (tinción de
Gram).
|
|

MAL ROJO:
E. rhusiopathiae, crecimiento en Agar Sangre.
|
Imprimir
|